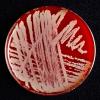

Long COVID: grip op de aantallen en risicofactoren in Nederland / IB 10-2021
Extreem moe, benauwd en vergeetachtig; een deel van de mensen houdt na een besmetting met het coronavirus nog langdurig gezondheidsklachten.

Extreem moe, benauwd en vergeetachtig; een deel van de mensen houdt na een besmetting met het coronavirus nog langdurig gezondheidsklachten.

Het Centraal Bureau voor de Statistiek (CBS) schatte dat er in de eerste 9 weken van de corona-epidemie (week 11 tot en met week 19) 32% meer mensen zijn overleden dan men in deze periode zou verwachten als er geen epidemie was geweest.

Tot en met 21 september 2021 zijn er in Nederland 192.227 zorgmedewerkers in de leeftijd van 18 t/m 69 jaar met een positieve testuitslag voor SARS-CoV-2 gemeld aan het RIVM.
De landelijke vaccinatiegraad voor humaan papillomavirus (HPV) is een stuk lager dan de vaccinatiegraad van andere infectieziekten.

In de zomer van 2020 kwam bij de afdeling algemene infectieziektebestrijding van de GGD Haaglanden een melding binnen van een uitbraak van gastro-enteritis in een instelling voor verstandelijk en lichamelijk gehandicapte mensen.

Antibioticaresistentie is een van de grootste bedreigingen van de volksgezondheid. (1) In Nederland is de prevalentie van bijzondere resistente micro-organismen (BRMO) relatief laag.

In december 2019 werd voor het eerst melding gemaakt van een onbekende besmettelijke luchtweginfectie in Wuhan.

Met de klok mee, beginnend linksboven: Jossy van den Boogaard, Jeroen Kuiper, Roelien Beuker, Ellen Generaal, Suhreta Mujakovic, Juul Tönis, Femke Koedijk, Hans Augustijn.

Overzicht van bijzondere meldingen, clusters en epidemieën van infectieziekten in binnen- en buitenland tot en met 10 december 2020.

Na een jarenlange continu dalende trend in Nederland van Salmonella-infecties bij de mens is het aantal sinds 2013 gestabiliseerd op ruim 1500 laboratoriumbevestigde patiënten per jaar met een geschatte 26.000 patiënten in de gehele bevolking. Deze stabilisatie komt overeen met het beeld dat wordt gezien in de monitoring van landbouwhuisdieren en levensmiddelen.